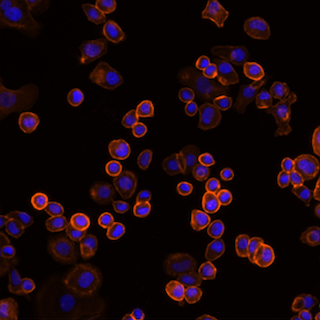
Zenon Alexa Fluor Plus Microscope image of fluorescently labeled SKBR3 Cells

Search
Search

Antibody Labeling Kits |
In addition to exceptional brightness and photostability, our customers can get access to an experienced, problem-solving technical support team, application and experimental tips, and protocols to help with experimental planning.
Precise antibody conjugation in as little as four hours.
Not sure which type of conjugation kit to use? Explore the table and sections below to find the right antibody conjugation kit for your application.
| Zip Rapid Antibody Labeling Kits | Zenon Antibody Labeling Kits | |
|---|---|---|
| Amount IgG labeled/reaction* | 100 µg | 1–20 µg |
| Label target/method | Free lysines/covalent amine-reactive chemistry | Fc portion of IgG/antibody affinity |
| Can measure degree of labeling? | No | No |
| Can store conjugate more than 24 hr? | Yes | No |
| Site-specific label? | No | No |
| Compatible with BSA or other stabilizers in sample buffer? | No | Yes |
| Requires post-label purification? | No | No |
| Time required for protocol | 15 min | 5 min |
| Optimal applications** | FC, IF, WB, HCA | FC, IF, WB, HCA |
| *Kits are optimized for whole IgG protein, molecular weight 150 kDa unless otherwise indicated. For those kits, please see instructions on how to adjust protein concentration for optimal dye:protein ratios. | ||
| **FC=flow cytometry; IF=immunofluorescence; WB=western blot analysis; HCA=high content analysis | ||
| Alexa Fluor Antibody Labeling Kits | Zip Rapid Antibody Labeling Kits | Large-scale antibody labeling kits | ReadyLabel Antibody Labeling Kits | |
|---|---|---|---|---|
| Amount IgG labeled/reaction* | 100 µg | 100 µg | 1 mg | 20 or 100 µg |
| Label target/method | Free lysines/covalent amine-reactive chemistry | |||
| Can measure degree of labeling? | Yes | No | Yes | Yes |
| Can store conjugate more than 24 hr? | Yes | Yes | Yes | Yes |
| Site-specific label? | No | No | No | No |
| Compatible with BSA or other stabilizers in sample buffer? | No | No | No | Yes |
| Requires post-label purification? | Yes - included | No | Yes - included | Yes - included |
| Time required for protocol | 30 min | 15 min | 60 min | 60 min |
| Optimal applications** | FC, IF, WB, HCA | FC, IF, WB, HCA | FC, IF, WB, HCA | FC, IF, WB, HCA |
| *Kits are optimized for whole IgG protein, molecular weight 150 kDa unless otherwise indicated. For those kits, please see instructions on how to adjust protein concentration for optimal dye:protein ratios. | ||||
| **FC=flow cytometry; IF=immunofluorescence; WB=western blot analysis; HCA=high content analysis | ||||
| SiteClick Antibody Labeling Kits | |
|---|---|
| Amount IgG labeled/reaction* | 100 µg–5 mg |
| Label target/method | Carbohydrates on IgG heavy chain/covalent, copper-free click chemistry |
| Can measure degree of labeling? | Yes |
| Can store conjugate more than 24 hr? | Yes |
| Site-specific label? | Yes |
| Compatible with BSA or other stabilizers in sample buffer? | Yes |
| Requires post-label purification? | Yes - included |
| Time required for protocol | Duet kits: 6–8 hours; Quartet kits: 16–18 hours |
| Optimal applications** | FC, IF, WB, HCA |
| *Kits are optimized for whole IgG protein, molecular weight 150 kDa unless otherwise indicated. For those kits, please see instructions on how to adjust protein concentration for optimal dye:protein ratios. | |
| **FC=flow cytometry; IF=immunofluorescence; WB=western blot analysis; HCA=high content analysis | |
| Zenon Antibody Labeling Kits | ReadyLabel Antibody Labeling Kits | |
|---|---|---|
| Amount IgG labeled/reaction* | 1–20 µg (96 labelings) | 20 or 100 µg (5 labelings) |
| Label target/method | Fc portion of IgG/antibody affinity | Free lysines/covalent amine-reactive chemistry |
| Can measure degree of labeling? | No | Yes |
| Can store conjugate more than 24 hr? | No | Yes |
| Site-specific label? | No | No |
| Compatible with BSA or other stabilizers in sample buffer? | Yes | Yes |
| Requires post-label purification? | No | Yes—included |
| Time required for protocol | 5 min | 60 min |
| Optimal applications** | FC, IF, WB, HCA | FC, IF, WB, HCA |
| *Kits are optimized for whole IgG protein, molecular weight 150 kDa unless otherwise indicated. For those kits, please see instructions on how to adjust protein concentration for optimal dye:protein ratios. | ||
| **FC=flow cytometry; IF=immunofluorescence; WB=western blot analysis; HCA=high content analysis | ||
| SiteClick Lysolight Labeling Kits | Zenon Lysolight Labeling Kits | pHrodo Antibody Labeling Kits | SiteClick pHrodo Antibody Labeling Kits | Zenon pHrodo Antibody Labeling Reagents | |
|---|---|---|---|---|---|
| Amount IgG labeled/reaction* | 100 µg–5 mg | 1–20 µg | 20 µg–1 mg | 100 µg–5 mg | 1–20 µg |
| Label target/method | Fc portion of IgG | Fc portion of IgG/antibody affinity | Free lysines/covalent amine-reactive chemistry | Fc portion of IgG | Fc portion of IgG/antibody affinity |
| Can measure degree of labeling? | Yes | No | Yes | Yes | No |
| Can store conjugate more than 24 hr? | Yes | No | Yes | Yes | No |
| Site-specific label? | Yes | No | No | Yes | No |
| Compatible with BSA or other stabilizers in sample buffer? | Yes | Yes | No | Yes | Yes |
| Requires post-label purification? | Yes | No | Yes—included | Yes—included | No |
| Time required for protocol | 6 hours | 5 min | 60 min | Overnight incubation | 5 min |
| Optimal applications** | FC, IF, WB, HCA | FC, IF, WB, HCA | FC, IF, WB, HCA | FC, IF, WB, HCA | FC, IF, WB, HCA |
| *Kits are optimized for whole IgG protein, molecular weight 150 kDa unless otherwise indicated. For those kits, please see instructions on how to adjust protein concentration for optimal dye:protein ratios. | |||||
| **FC=flow cytometry; IF=immunofluorescence; WB=western blot analysis; HCA=high content analysis | |||||
| Zip Rapid Antibody Labeling Kits | Zenon Antibody Labeling Kits | |
|---|---|---|
| Amount IgG labeled/reaction* | 100 µg | 1–20 µg |
| Label target/method | Free lysines/covalent amine-reactive chemistry | Fc portion of IgG/antibody affinity |
| Can measure degree of labeling? | No | No |
| Can store conjugate more than 24 hr? | Yes | No |
| Site-specific label? | No | No |
| Compatible with BSA or other stabilizers in sample buffer? | No | Yes |
| Requires post-label purification? | No | No |
| Time required for protocol | 15 min | 5 min |
| Optimal applications** | FC, IF, WB, HCA | FC, IF, WB, HCA |
| *Kits are optimized for whole IgG protein, molecular weight 150 kDa unless otherwise indicated. For those kits, please see instructions on how to adjust protein concentration for optimal dye:protein ratios. | ||
| **FC=flow cytometry; IF=immunofluorescence; WB=western blot analysis; HCA=high content analysis | ||
| Alexa Fluor Antibody Labeling Kits | Zip Rapid Antibody Labeling Kits | Large-scale antibody labeling kits | ReadyLabel Antibody Labeling Kits | |
|---|---|---|---|---|
| Amount IgG labeled/reaction* | 100 µg | 100 µg | 1 mg | 20 or 100 µg |
| Label target/method | Free lysines/covalent amine-reactive chemistry | |||
| Can measure degree of labeling? | Yes | No | Yes | Yes |
| Can store conjugate more than 24 hr? | Yes | Yes | Yes | Yes |
| Site-specific label? | No | No | No | No |
| Compatible with BSA or other stabilizers in sample buffer? | No | No | No | Yes |
| Requires post-label purification? | Yes - included | No | Yes - included | Yes - included |
| Time required for protocol | 30 min | 15 min | 60 min | 60 min |
| Optimal applications** | FC, IF, WB, HCA | FC, IF, WB, HCA | FC, IF, WB, HCA | FC, IF, WB, HCA |
| *Kits are optimized for whole IgG protein, molecular weight 150 kDa unless otherwise indicated. For those kits, please see instructions on how to adjust protein concentration for optimal dye:protein ratios. | ||||
| **FC=flow cytometry; IF=immunofluorescence; WB=western blot analysis; HCA=high content analysis | ||||
| SiteClick Antibody Labeling Kits | |
|---|---|
| Amount IgG labeled/reaction* | 100 µg–5 mg |
| Label target/method | Carbohydrates on IgG heavy chain/covalent, copper-free click chemistry |
| Can measure degree of labeling? | Yes |
| Can store conjugate more than 24 hr? | Yes |
| Site-specific label? | Yes |
| Compatible with BSA or other stabilizers in sample buffer? | Yes |
| Requires post-label purification? | Yes - included |
| Time required for protocol | Duet kits: 6–8 hours; Quartet kits: 16–18 hours |
| Optimal applications** | FC, IF, WB, HCA |
| *Kits are optimized for whole IgG protein, molecular weight 150 kDa unless otherwise indicated. For those kits, please see instructions on how to adjust protein concentration for optimal dye:protein ratios. | |
| **FC=flow cytometry; IF=immunofluorescence; WB=western blot analysis; HCA=high content analysis | |
| Zenon Antibody Labeling Kits | ReadyLabel Antibody Labeling Kits | |
|---|---|---|
| Amount IgG labeled/reaction* | 1–20 µg (96 labelings) | 20 or 100 µg (5 labelings) |
| Label target/method | Fc portion of IgG/antibody affinity | Free lysines/covalent amine-reactive chemistry |
| Can measure degree of labeling? | No | Yes |
| Can store conjugate more than 24 hr? | No | Yes |
| Site-specific label? | No | No |
| Compatible with BSA or other stabilizers in sample buffer? | Yes | Yes |
| Requires post-label purification? | No | Yes—included |
| Time required for protocol | 5 min | 60 min |
| Optimal applications** | FC, IF, WB, HCA | FC, IF, WB, HCA |
| *Kits are optimized for whole IgG protein, molecular weight 150 kDa unless otherwise indicated. For those kits, please see instructions on how to adjust protein concentration for optimal dye:protein ratios. | ||
| **FC=flow cytometry; IF=immunofluorescence; WB=western blot analysis; HCA=high content analysis | ||
| SiteClick Lysolight Labeling Kits | Zenon Lysolight Labeling Kits | pHrodo Antibody Labeling Kits | SiteClick pHrodo Antibody Labeling Kits | Zenon pHrodo Antibody Labeling Reagents | |
|---|---|---|---|---|---|
| Amount IgG labeled/reaction* | 100 µg–5 mg | 1–20 µg | 20 µg–1 mg | 100 µg–5 mg | 1–20 µg |
| Label target/method | Fc portion of IgG | Fc portion of IgG/antibody affinity | Free lysines/covalent amine-reactive chemistry | Fc portion of IgG | Fc portion of IgG/antibody affinity |
| Can measure degree of labeling? | Yes | No | Yes | Yes | No |
| Can store conjugate more than 24 hr? | Yes | No | Yes | Yes | No |
| Site-specific label? | Yes | No | No | Yes | No |
| Compatible with BSA or other stabilizers in sample buffer? | Yes | Yes | No | Yes | Yes |
| Requires post-label purification? | Yes | No | Yes—included | Yes—included | No |
| Time required for protocol | 6 hours | 5 min | 60 min | Overnight incubation | 5 min |
| Optimal applications** | FC, IF, WB, HCA | FC, IF, WB, HCA | FC, IF, WB, HCA | FC, IF, WB, HCA | FC, IF, WB, HCA |
| *Kits are optimized for whole IgG protein, molecular weight 150 kDa unless otherwise indicated. For those kits, please see instructions on how to adjust protein concentration for optimal dye:protein ratios. | |||||
| **FC=flow cytometry; IF=immunofluorescence; WB=western blot analysis; HCA=high content analysis | |||||
For flow cytometry antibody conjugation, see the NovaFluor Dyes for Immunophenotyping which are designed for more resolution with narrow emission spectra and minimal cross-laser excitation.
Find DyLight antibody labeling kits for labeling 1 mg or 100 μg of antibody with DyLight fluorophores across the spectrum.
Find standalone amine-reactive dyes and more information about amine-reactive chemistries in Fluorophores and Their Amine-Reactive Derivatives—Chapter 1, The Molecular Probes Handbook.
We also have thiol-reactive dyes available as standalone reagents and you can learn more about these in the Thiol-Reactive Probes—Chapter 2, The Molecular Probes Handbook.
Zip Alexa Fluor Rapid Antibody Labeling Kits allow you to efficiently label your precious antibody with fluorescent dyes to create an antibody conjugate that is ready to use within 15 minutes.
The kit contains everything you need to perform three separate labeling reactions. Covalently labeled conjugates are exceptional for multiple applications, including flow cytometry, fluorescence microscopy, immunohistochemistry, primary antibody detection, ELISAs, immunocytochemistry, and indirect FISH. Simply add 1 mL water to component A containing Zip buffer, add 1 mg of antibody, incubate for 15 minutes, and your antibody is ready to use (Figure 1).
Ex/Em = Fluorescence excitation and emission maxima, in nm.
Find more information about Alexa Fluor dyes and other fluorophores in the Fluorophore Selection Guide
Invitrogen Alexa Fluor Antibody labeling kits are easy-to-use kits to covalently label primary antibodies with Alexa Fluor dyes. Each antibody labeling kit includes everything needed to perform up to three separate antibody conjugation reactions. The kits also now include pre-assembled and pre-filled spin columns to more easily and quickly purify out free dye from your sample.
Alexa Fluor Antibody Labeling kits use amine-reactive chemistry to covalently attach Alexa Fluor dyes or a biotin molecule to your IgG antibody. For best results, ensure your primary antibody is in a compatible buffer, free of BSA or other protein stabilizers. If your antibody of interest needs clean-up, you can achieve this using antibody clean-up kits (Cat. No 89950, Cat No. 78609, or Cat No. 45206)
The first step in the conjugation workflow (Figure 2) is adding the included sodium bicarbonate to the primary antibody solution. This prepares the antibody for conjugation by enhancing the reactivity of the antibody's lysine residues.
The second step is to mix this solution with the included amine-reactive Alexa Fluor dye or biotin compound. The reactive groups on the fluorescent dye will attach to the primary amines on the IgG antibody's side chains. This creates a stable amide bond that covalently conjugates the fluorescent dye or biotin to the antibody. The conjugation reaction completes efficiently at room temperature after 15 minutes of incubation.
The final step is to remove the free or unbound dye which helps reduce background signal in your downstream applications. Each kit includes improved purification spin columns to help you achieve this. The pre-filled, pre-assembled columns are now compatible with standard microcentrifuges, helping save you time and lab space.
Figure 2. Overview of Alexa Fluor Antibody Labeling Kits process. Simply adjust the protein concentration to ~1 mg/mL in the provided buffer, then add it to a vial of amine-reactive dye. Purification is accomplished on the included Zeba Dye and Biotin removal columns optimized for ≥7 kDa proteins.
| Label | Ex/Em | Cat. No. |
|---|---|---|
| Alexa Fluor 350 | 346/442 | A88061 |
| Alexa Fluor 488 | 494/519 | A88062 |
| Alexa Fluor 532 | 530/554 | A88063 |
| Alexa Fluor 546 | 554/570 | A88064 |
| Alexa Fluor 555 | 555/565 | A88065 |
| Alexa Fluor 568 | 577/603 | A88066 |
| Alexa Fluor 594 | 590/617 | A88067 |
| Alexa Fluor 647 | 650/668 | A88068 |
| Alexa Fluor 680 | 679/702 | A88069 |
| Alexa Fluor 790 | 785/810 | A88070 |
| Biotin | N/A | B88060 |
| Pacific Blue dye | 410/455 | P30013 |
| Pacific Orange Dye | 405/551 | P30014 |
Ex/Em = Fluorescence excitation and emission maxima, in nm.
Find more information about Alexa Fluor dyes and other fluorophores in the Fluorophore Selection Guide
Invitrogen ReadyLabel Antibody Labeling Kits provide a 2-in-1 antibody labeling and purification kit, to label antibodies directly in presence of impurities like BSA and other protein stabilizers without compromising signal to background.
Our ReadyLabel dyes are now available in expanded dye formats optimized for spectral unmixing, to enable primary antibody detection for your multiplex or spatial biology experiments.
ReadyLabel Antibody Labeling Kits allow for fast, convenient antibody conjugation of off-the-shelf antibodies and cell culture supernatants without prior purification of the antibody solution. This works because the provided ReadyLabel spin columns contain resin that filter out contaminating stabilizer proteins present in the antibody solution (Figure 3). The resulting covalently bonded antibody conjugate can be used with flow cytometry, western blotting, ELISA, and indirect FISH.
ReadyLabel kits are equipped with your choice of our most popular stains to produce high yields of bright, soluble conjugates. Need a different dye? Consider our ReadyLabel Flex Kits, which contain everything needed except the dye, and use a dye of your choice. Our most popular ReadyLabel Kits (Alexa Fluor 488, Alexa Fluor 647, Biotin, and Flex) are available in two different pack sizes (20 μg or 100 μg IgG per reaction) and include all components necessary for five labeling reactions. Our ReadyLabel kits designed for high-plex staining or spatial biology workflows are available in the 20 μg pack size.
Figure 3. Antibodies are often stored with BSA or other protein stabilizers to prevent degradation. ReadyLabel kits are equipped with resin-containing spin columns that capture these contaminants and allow you to skip the purification step of your antibody solution. With approximately 20 minutes of hands-on time, and 30 minutes of incubation at room temperature, your covalently bonded antibody conjugate is now ready to use.
ReadyLabel Antibody Labeling Kits offer an exceptional advantage for multiplex or high-plex experiments. Unlike secondary detection methods, which are often constrained by the number of available IgG species, our kits allow you to directly conjugate your primary antibodies of your choice, filling gaps in your panels. This means you can achieve higher levels of multiplexing with greater flexibility.
Designed with high-quality, bright dyes, optimized for spectral unmixing, and a focus on minimizing background noise through BSA removal, our kits enable clear and precise signals in your experiments. This clarity enhances the reliability and accuracy of your results, making ReadyLabel Antibody Labeling Kits well suited for multiplexing applications.
Visit our spatial biology resource center to learn more
Download the Application Note: Streamlined spatial analysis of the brain tumor microenvironment and associated pathological states using multiplex immunohistochemistry
Figure 4. Imaged on the EVOS S1000 Spatial Imaging Instrument at 20x, FFPE human colon tissue was stained using ReadyLabel Kits. ReadyLabel Alexa Fluor 420 SMA, ReadyLabel Alexa Fluor 514 CD20, ReadyLabel Alexa Fluor Plus 555 PCNA, ReadyLabel Alexa Fluor 594 CD45RB, ReadyLabel Alexa Fluor 647 eCadherin, ReadyLabel Alexa Fluor 700 Cytokeratin, and ReadyLabel Alexa Fluor Plus 750 CD68.
Figure 5. Imaged on the EVOS S1000 Spatial Imaging Instrument at 20x, FFPE Human brain tissue with Parkinson’s disease was stained using a mix of conjugated primary antibodies and ReadyLabel kits. DAPI, Alexa Fluor 420 CD68, Alexa Fluor 488 GFAP, Alexa Fluor Plus 555 Ki67, ReadyLabel Alexa Fluor 594 LRRK2, ReadyLabel Alexa Fluor 647 alpha Synuclein, Alexa Fluor 700 p53, and Alexa Fluor Plus 750 Vimentin.
Figure 6. Imaged on the EVOS S1000 Spatial Imaging Instrument at 20x, FFPE human tonsil tissue was stained using ReadyLabel Kits. ReadyLabel Alexa Fluor 420 SMA, ReadyLabel Alexa Fluor 514 CD20, ReadyLabel Alexa Fluor Plus 555 PCNA, ReadyLabel Alexa Fluor 594 CD45RB, ReadyLabel Alexa Fluor 647 eCadherin, ReadyLabel Alexa Fluor 700 Cytokeratin, and ReadyLabel Alexa Fluor Plus 750 CD68.
Figure 7. Imaged on the EVOS S1000 Spatial Imaging Instrument at 20x, FFPE human colon tissue was stained using ReadyLabel Kits. ReadyLabel Alexa Fluor 420 GranzymeB, ReadyLabel Alexa Fluor 514 Cytokeratin, ReadyLabel Alexa Fluor Plus 555 PCNA, ReadyLabel Alexa Fluor 594 HLA-DR, ReadyLabel Alexa Fluor 647 eCadherin, ReadyLabel Alexa Fluor 700 SMA, and ReadyLabel Alexa Fluor Plus 750 CD68.
Thermo Fisher Scientific large-scale antibody or protein labeling kits provide a nearly effortless way to covalently label 1 mg of IgG antibody with a fluorescent dye (including Alexa Fluor dyes) or biotin.
The large-scale antibody or protein labeling kits utilize an amine-reactive fluorophore or hapten to covalently attach the label to the IgG antibody. Once formed, the covalent bond between the label and the protein is extremely stable—you are using the same chemistry we use to prepare our own primary and secondary conjugates.
Simply add ~1 mg of purified IgG (in ~500 μL and free of amine-containing buffers such as Tris) to one of the vials containing a premeasured quantity of amine-reactive dye and a magnetic stir bar. Purification is accomplished by a pre-packed spin column supplied with the kit and affords high antibody recovery (typically >85%). The entire labeling and purification procedure can be completed in as little as 90 minutes (approximately 15 mins hands-on time). Removal of free dye is essential for the determination of the degree of labeling (DOL). Everything needed to perform three conjugations is provided.
Figure 5. Overview of the large-scale antibody labeling kits process. Adjust the protein concentration to ~2 mg/mL, add provided bicarbonate, then add the solution to the vial of reactive dye. Purification is accomplished using a pre-packed spin column that is compatible with proteins ≥20 kDa.
| Label | Ex/Em | Cat. No. |
|---|---|---|
| Alexa Fluor 350 | 346/442 | A10170 |
| Alexa Fluor 488 | 495/519 | A10235 |
| Alexa Fluor 532 | 532/553 | A10236 |
| Alexa Fluor 546 | 556/573 | A10237 |
| Alexa Fluor 555 | 555/565 | A20174 |
| Alexa Fluor 568 | 578/603 | A10238 |
| Alexa Fluor 594 | 590/617 | A10239 |
| Alexa Fluor 633 | 621/639 | A20170 |
| Alexa Fluor 647 | 650/665 | A20173 |
| Alexa Fluor 660 | 663/690 | A20171 |
| Alexa Fluor 680 | 679/702 | A20172 |
| Fluorescein | 494/518 | F10240 |
| Oregon Green 488 | 496/524 | O10241 |
| Pacific Blue dye | 410/455 | P30012 |
| Pacific Orange dye | 400/551 | P30016 |
| Texas Red dye | 595/615 | T10244 |
| Biotin | NA | D20655 |
Ex/Em = Fluorescence excitation and emission maxima, in nm.
Find more information about Alexa Fluor dyes and other fluorophores in the Fluorophore Selection Guide
Invitrogen Zenon labeling technology rapidly conjugates antibodies to a variety of fluorochromes, even from minimal, unpurified sources like hybridoma culture supernatant. Designed to bind to the Fc portion of primary antibodies, Zenon fragments enable specific, noncovalent labeling of small antibody quantities without compromising antibody function. Zenon Alexa Fluor Plus labeling reagents merge Zenon technology's speed and scalability with the excellent performance of Alexa Fluor Plus dyes, offering an optimal system for screening antibody binding in therapeutic antibody discovery.
Invitrogen Zenon labeling reagents provide a quick and easy-to-use system to noncovalently label human, mouse, and rabbit IgG antibodies with a variety of fluorophores. Prelabeled Zenon Fab fragments are designed to rapidly bind to the Fc portion of IgG antibodies, preserving antibody function. Zenon Fab-antibody conjugation occurs in less than 5 minutes, with only a small amount of starting material needed and no purification steps required.
The Invitrogen Zenon Alexa Fluor Plus labeling reagents have been optimized to screen for antibody binding, giving a bright fluorescence-based indication of antibody binding. These reagents combine the rapid and scalable Zenon technology with the superior Alexa Fluor Plus fluorophores to provide a higher signal to noise ratio and to increase confidence in your screening results.
Want to learn more about screening for binding of therapeutic antibodies?
View our Scientific Poster for Antibody Labeling Reagents for Therapeutic Antibody Screening
| Reactivity | Target isotype | Find products |
|---|---|---|
| Mouse | IgG1 | See all kits |
| Human | IgG | See all kits |
| Rabbit | IgG | See all kits |
Thermo Fisher Scientific SiteClick labeling kits allow simple and gentle site-selective attachment of detection molecules to heavy chain N-linked glycans—far from the antigen-binding domain—providing excellent reproducibility from labeling to labeling and from antibody to antibody. A number of different detection molecules can be site-selectively attached to the heavy chain glycans—including phycobiliproteins (e.g., R-PE), QDot probes, Alexa Fluor dyes, pHrodo dye, metal-chelating compounds, and other small molecules like biotin—allowing multiplex analysis with antibodies from the same species. Features include:
In general, IgG antibodies contain two N-linked glycans attached to specific conserved asparagine residues located in the antibody heavy chain Fc domain. These sugar chains, predominantly complex biantennary glycans with two terminal branches, are structurally quite homogeneous, and the terminal sequences of the glycan branches are highly consistent. Most of the antibody glycan branches terminate with galactose-N-acetylglucosamine (Gal-GlcNAc-) or with N-acetylglucosamine (GlcNAc-). Removal of the terminal Gal residue with β-galactosidase unmasks the majority of terminal GlcNAc labeling sites for the subsequent enzymatic β-galactosyl transferase (GalT) reaction (Figure 8). After cleavage of terminal Gal residues by β-galactosidase, each N-linked glycan will contain, on average, 2 terminal GlcNAc residues per heavy chain (4 terminal GlcNAc per antibody). The azide-activated antibody can now be labeled with a dibenzocyclooctyne (DIBO)-functionalized probe using copper-free click chemistry (Figure 9).
The SiteClick method is compatible with antibodies from a number of different species including, but not limited to, human, rabbit, mouse, rat, goat, hamster, and chicken. Additionally, SiteClick labeling is effective with several antibody classes such as IgG, IgM, and IgY; note that chicken IgY antibodies have 6 heavy chain glycans instead of 2 and therefore can be labeled to a higher extent.
The SiteClick Antibody Labeling system is available in two formats:
This flexibility of formats allows several advantages including the ability to easily change the fluorescent dye used, without impacting the degree of labeling of the same antibody and the ability to prepare a large batch of modified antibody and label only a small amount as needed, again, preserving the consistency of degree of labeling and functionality.
The covalent and site-specific attachment of the dyes to the N-linked glycans on the antibody heavy chain Fc domain helps ensure the immunogenicity of the antigen binding site is preserved, resulting in more efficient binding to the antigen as compared to antibodies randomly labeled with amine-reactive dyes. In a side-by-side comparison of SiteClick-labeled and amine-reactive labeled anti-troponin 1 antibody, the sensitivity of the SiteClick-labeled antibody was greater than that of the amine-reactive labeled antibody (Figure 10).
Labeling antibodies with the SiteClick antibody labeling system helps give you confidence that the antibody will be labeled the same way every time, with no time needed for reaction optimization. This means the same number of dyes attached to each molecule, the same preservation of the antigen binding site, helping ensure the same results every time. An example of the consistency in labeling between different antibodies is shown in Figure 11.
Table 1. Antigenicity of primary antibodies labeled in degree of labeling study (Figure 11).
| Human IgG1 | Human IgG3 | Mouse IgG1 | Mouse IgG2a | Goat Polyclonal |
|---|---|---|---|---|
| EGFR | Lymphoma cell | GD2 | CD4 | Apolipoprotein-A2 |
| HER2/neu | GD3 | β-tubulin | CD3 | |
| sLea | sLea | CD8a | CD8 | |
| GD2 | f-GM1 | CD45 | CD56 | |
| GM2 | Tn | C3b, iC3b | C3b, iC3b, C3dg | |
| J591 | Interferon-γ |
| Product name | Antibody quantity labeled | Ex/Em* | Cat. No. |
|---|---|---|---|
| Kits for antibody modification only | |||
| SiteClick Quartet Antibody Modification Kit | 100 μg | N/A | S11003 |
| 1 mg | S11002 | ||
| 5 mg | S11001 | ||
| 3 x 100 μg | S11007 | ||
| SiteClick Duet Antibody Modification Kit | 100 μg | N/A | S11006 |
| 1 mg | S11005 | ||
| 5 mg | S11004 | ||
| 3 x 100 μg | S11008 | ||
| Standalone labeling reagents | |||
| SiteClick LysoLight Green sDBCO | 100 μg | 488/525 | L36009 |
| 500 μg | L36010 | ||
| LysoLight Deep Red sDBCO | 100 μg | 650/668 | L36011 |
| 500 μg | L36012 | ||
| Zenon LysoLight Green Human IgG Labeling Reagent | 240 µL | 488/525 | Z25627 |
| 1.2 mL | Z25628 | ||
| Zenon LysoLight Green Human IgG Labeling Reagent | 240 µL | 488/525 | Z25629 |
| 1.2 mL | Z25630 | ||
| SiteClick Alexa Fluor 488 sDIBO Alkyne | 100 μg | 495/519 | C20027 |
| 1 mg | S10904 | ||
| 5 mg | S10909 | ||
| SiteClick Alexa Fluor 555 sDIBO Alkyne | 100 μg | 555/565 | C20028 |
| SiteClick Alexa Fluor 647 sDIBO Alkyne | 100 μg | 650/665 | C20029 |
| 1 mg | S10906 | ||
| 5 mg | S10911 | ||
| SiteClick iFL pHrodo Red sDIBO Alkyne | 100 μg | 560/585 | C20034 |
| 1 mg | S10903 | ||
| 5 mg | S10908 | ||
| SiteClick iFL pHrodo Deep Red sDIBO Alkyne | 100 μg | 640/655 | S10914 |
| 1 mg | S10915 | ||
| SiteClick Biotin sDIBO Alkyne | 100 μg | N/A | C20030 |
| 1 mg | S10902 | ||
| 5 mg | S10907 | ||
| SiteClick Amine sDIBO Alkyne | 100 μg | N/A | C20031 |
| Kits containing antibody modification + labeling reagent | |||
| SiteClick R-PE Antibody Labeling kit | 100 μg | 565/578 | S10467 |
| SiteClick Qdot 525 Antibody Labeling kit | 100 μg | 405/525 | S10449 |
| SiteClick Qdot 565 Antibody Labeling kit | 100 μg | 405/565 | S10450 |
| SiteClick Qdot 585 Antibody Labeling kit | 100 μg | 405/585 | S10451 |
| SiteClick Qdot 605 Antibody Labeling kit | 100 μg | 405/605 | S10469 |
| SiteClick Qdot 625 Antibody Labeling kit | 100 μg | 405/625 | S10452 |
| SiteClick Qdot 655 Antibody Labeling kit | 100 μg | 405/655 | S10453 |
| SiteClick Qdot 705 Antibody Labeling kit | 100 μg | 405/705 | S10454 |
| SiteClick Qdot 800 Antibody Labeling kit | 100 μg | 405/800 | S10455 |
| SiteClick Biotin Antibody Labeling Kit | 100 μg | N/A | S20033 |
*Ex/Em = Fluorescence excitation and emission maxima, in nm.
Find more information about Alexa Fluor dyes and other fluorophores in the Fluorophore Selection Guide
For Research Use Only. Not for use in diagnostic procedures.